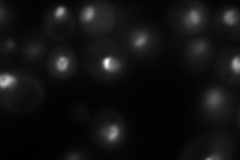
YPR110C

View description
RNA polymerase subunit AC40, common to RNA polymerase I and III
Localization:
Intensity:
Fold change:
Significance:
-
C’ GFP library in SD

nucleus140.01 -
N' NOP1pr-GFP in SD
nucleus,nucleolus151.73 -
N' TEF2pr-mCherry in SD

nucleus,nucleolus0 -
N' NATIVEpr-GFP in SD

nucleus,nucleolus125.096 -
N' TEF2pr-VC and Cyto-VN in SD

nucleolus48.493 -
C’ GFP library in SD+DTT

nucleus120.40.85No -
C’ GFP library in SD+H2O2

nucleus162.341.15No -
C’ GFP library in Starvation Media

nucleus91.540.65No -
C’ GFP library on the background of Pup2-DaMP

nucleus -
C’ GFP library on the background of CCT mutant

nucleus161.2641.15171No
